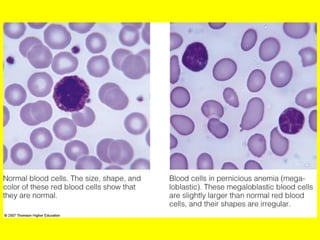
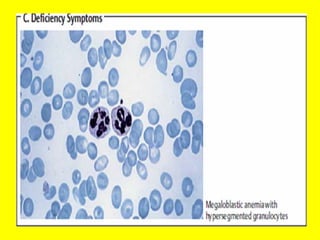

Vitamin B12 deficiency is the most likely diagnosis for this patient based on her history, examination findings, and laboratory results. The underlying problem is likely inadequate dietary intake of vitamin B12 as a result of her vegan diet. The two most common causes of megaloblastic anemia are vitamin B12 deficiency and folate deficiency. However, her history of fatigue, numbness, diarrhea, weight loss, and beefy red tongue point more specifically to vitamin B12 deficiency, as folate deficiency would be less likely given her dietary habits.





















![4. Addisonian anemia is pernicious [fatal] without
any remedy. It is manifested in persons 40
years of age. It is an autoimmune disease and
antibodies are formed against IF. The
deficiency of IF leads to defective absorption of
B12.
5. Atrophy of gastric epithelium: It leads to
decreased IF and decreased absorption of
B12.](https://image.slidesharecdn.com/vitb12-130516102136-phpapp02/85/Vitamin-B12-MUHAMMAD-MUSTANSAR-22-320.jpg)